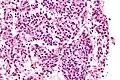
Very high magnification

| Typical pulmonary carcinoid tumour | |
|---|---|
| Other names | Typical lung carcinoid tumour, lung carcinoid, typical lung carcinoid |
 | |
| Micrograph of a typical pulmonary carcinoid tumour. | |
| Specialty | Oncology |
Typical pulmonary carcinoid tumour is a subtype of pulmonary carcinoid tumour. It is an uncommon low-grade malignant lung mass that is most often in the central airways of the lung.[1]
Signs and symptoms
Lung carcinoids typically present with a cough or hemoptysis.[2] Findings may closely mimic malignant tumours of the lung, i.e. lung cancer.
Diagnosis
.jpg.webp)
The definitive diagnosis is rendered by a microscopic examination, after excision. Typical carcinoids have cells with stippled chromatin and a moderate quantity of cytoplasm. They typically have few mitoses and lack necrosis. By definition, they are greater than 4 mm in largest dimension; smaller lesions are referred to as pulmonary carcinoid tumourlets.
The differential diagnosis of typical pulmonary carcinoid tumour includes: atypical pulmonary carcinoid tumour, pulmonary carcinoid tumourlet and lung adenocarcinoma.
Very high magnification
Very high magnification With prominent rosettes
With prominent rosettes
Treatment
Typical carcinoids are usually treated with surgical excision.
See also
References
- ↑ Meisinger QC, Klein JS, Butnor KJ, Gentchos G, Leavitt BJ (November 2011). "CT features of peripheral pulmonary carcinoid tumors". AJR. American Journal of Roentgenology. 197 (5): 1073–1080. doi:10.2214/AJR.10.5954. PMID 22021498.
- ↑ Gungor S, Damadoglu E, Aybatli A, Yilmaz A, Kir A, Akkaya E (July 2006). "Typical pulmonary carcinoid tumors: presentation and outcome of 24 cases". Medical Science Monitor. 12 (7): CR315–CR318. PMID 16810137.